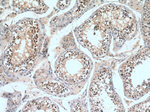
STAG3 Antibody in Immunohistochemistry (Paraffin) (IHC (P))
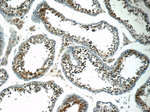
STAG3 Antibody in Immunohistochemistry (Paraffin) (IHC (P))

Search
Proteintech
STAG3 Polyclonal Antibody
{{$productOrderCtrl.translations['antibody.pdp.commerceCard.promotion.promotions']}}
{{$productOrderCtrl.translations['antibody.pdp.commerceCard.promotion.viewpromo']}}
{{$productOrderCtrl.translations['antibody.pdp.commerceCard.promotion.promocode']}}: {{promo.promoCode}} {{promo.promoTitle}} {{promo.promoDescription}}. {{$productOrderCtrl.translations['antibody.pdp.commerceCard.promotion.learnmore']}}
产品信息
23314-1-AP
种属反应
宿主/亚型
分类
类型
抗原
偶联物
形式
浓度
规格
纯化类型
保存液
内含物
保存条件
运输条件
产品详细信息
Immunogen sequence: RILLLSLKQ LYTELLQEHG PQGLNELPAF IEMRDLARRF ALSFGPQQLQ NRDLVVMLHK EGIQFSLSEL PPAGSSNQPP NLAFLELLSE FSPRLFHQDK QLLLSYLEKC LQHVSQAPGH PWGPVTTYCH SLSPVENTAE TSPQVLPSSK RRRVEGPAKP NREDVSSSQE ESLQLNSIPP TPTLTSTAVK SRQPLWGLKE MEEEDGSELD FAQGQPVAGT ERSRFLGPQY FQTPHNPSGP GLGNQLMRLS LMEEDEEEEL EIQDESNEER QDTDMQASSY SSTSERGLDL LDSTELDIED F (926-1225 aa encoded by BC146806)
靶标信息
STAG3 is a meiosis specific component of cohesin complex. The cohesin complex is required for the cohesion of sister chromatids after DNA replication. The cohesin complex apparently forms a large proteinaceous ring within which sister chromatids can be trapped. At anaphase, the complex is cleaved and dissociates from chromatin, allowing sister chromatids to segregate. The meiosis-specific cohesin complex probably replaces mitosis specific cohesin complex when it dissociates from chromatin during prophase I.
仅用于科研。不用于诊断过程。未经明确授权不得转售。
生物信息学
蛋白别名: Cohesin subunit SA-3; MGC119262; MGC119264; MGC119265; NHLRC 1; SCC3 homolog 3; Stromal antigen 3; Stromalin 3; Stromalin-3; unnamed protein product
基因别名: SA3; SPGF61; STAG3
UniProt ID: (Human) Q9UJ98
Entrez Gene ID: (Human) 10734